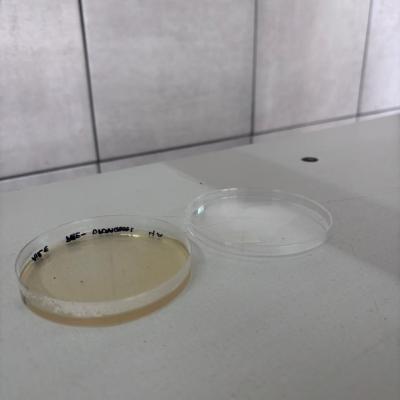
Actividad Extension Lta Coope Estandiltomate 17
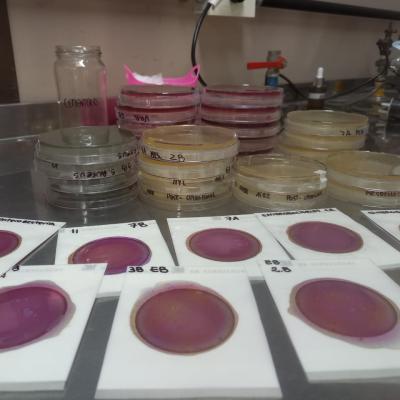
Analisis Lta Cooperativa 2

Práctica profesional con impacto social
En el marco del Trayecto Formativo Transversal de la Profesionalidad (TFTP), los/as estudiantes de 2° año de la Licenciatura en Tecnología de los Alimentos (LTA) han iniciado una Práctica Socio-Educativa (PSE) clave centrada en la "Verificación de un programa de limpieza y desinfección en un establecimiento comunitario elaborador de alimentos".
Esta actividad, concebida como una estrategia sistemática de enseñanza y aprendizaje, busca que los futuros profesionales de la Tecnología de Alimentos interactúen con problemáticas reales y se formen de manera integral, capaces de resolver situaciones específicas de manera autónoma.
El objetivo principal es la formación de un/a profesional comprometido/a con el contexto social en el que ejercerá su profesión.
Foco en la Economía Social y Solidaria
La PSE se desarrolla con la meta de reconocer espacios alternativos de elaboración de alimentos, específicamente enmarcados en la Economía Social y Solidaria.
La actividad se lleva a cabo en la cocina comunitaria de Tandil habilitada por la Dirección de Bromatología y Zoonosis, en colaboración con la cooperativa “EsTanDilTomate” un dispositivo de inclusión socio-laboral generado desde el Centro de Salud Comunitario del barrio Belgrano, dedicada a la elaboración de conservas. Esta cooperativa ha demandado asesoramiento específico para la optimización de sus procedimientos productivos.
La metodología de trabajo incluye una etapa inicial de sensibilización sobre establecimientos comunitarios de elaboración de alimentos, compartiendo nociones básicas de cooperativismo y explorando la posibilidad de una interacción enriquecedora con diversos actores de la comunidad.
Rigurosa Toma de Muestras y Análisis de Laboratorio
El corazón de la verificación reside en la toma y procesamiento de muestras, un procedimiento que involucra a estudiantes de distintos años.
Los estudiantes de 2° año de LTA están a cargo de tomar muestras pre-operacionales, mientras que estudiantes de 4° año de LTA recolectarán muestras post-operacionales.
Estas muestras se obtienen por la técnica de hisopado (swab) de distintas superficies, tanto inertes como vivas. Adicionalmente, se recolectarán muestras del ambiente. El procesamiento de todas las muestras se realiza en el Laboratorio de Microbiología de los Alimentos (FCV-UNCPBA), formando parte del “Trabajo Práctico N°9: Microbiología de superficies, ambientes y manipuladores”, que integra la cursada de Microbiología de los Alimentos (2° cuatrimestre).
El análisis busca identificar microorganismos indicadores de calidad e inocuidad, siguiendo una metodología analítica oficial. El proceso incluye la realización de diluciones y la siembra en diferentes medios de cultivos.

Impacto y Acreditación Profesional
Una vez obtenidos los resultados, y contrastándolos con los datos del proceso de validación del programa de limpieza y desinfección, los estudiantes se enfocarán en elaborar planes de acción y acompañamiento específicos para el establecimiento comunitario elaborador de alimentos.
Agradecemos a la Cooperativa “EsTanDilTomate” por abrirnos las puertas de su producción a la FCV UNICEN.